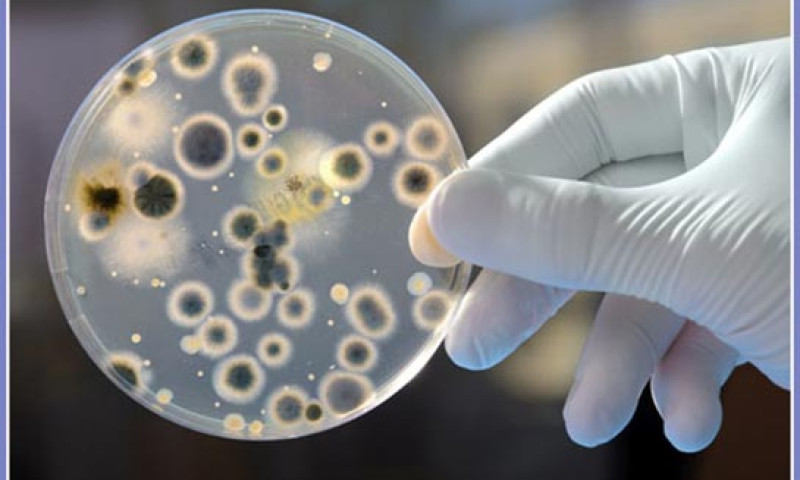

९२ प्रतिशत जारको पानीमा फोहोर र दिसामा पाईने जिवाणु–नास्ट
काठमाडौं,२८ वैशाख । हालै नेपाल विज्ञान तथा प्रविधि प्रज्ञा प्रतिष्ठान नास्टले गरेको एक अनुसन्धानमा नेपाली बजारमा विक्री हुने अधिकाँश जारको पानीमा दिसा र फोहोरमा पाइने जिवाणु भेटिएको छ ।
नाष्टले बेग्ला बेग्लै ५० ब्राण्डको पानी परीक्षण गरेकोमा ९२ प्रतिशतमा कोलिफर्म पाइएको छ । १ सय मिलिलिटर जारको पानीमा ३ सय भन्दा बढि समूहका झाडापखालाका जिवाणु भेटिएका हुन् । यसैगरी ७४ प्रतिशत पानीमा दिसामा पाइने इकोलाए नामक जिवाणु भेटिएका छन् ।
सरकारी मापदण्ड अनुसार पिउने पानीमा कोलिफर्म र इकोलाए यी दुवै जिवाणु शुन्य हुनुपर्दछ । यति मात्र होइन नास्टले अध्ययन गरेको पानी मध्ये अधिकाँशमा अम्लिएपना, छारिएपना, आइरन तथा फ्लोराइडको मात्रा पनि अत्याधिक नै रहेको छ । यी तत्व बढि भएको पानी पिएमा फोक्सोको रोग, घाँटीको चिल्लोपना घटाइदिने तथा हड्डी खिइने जस्ता रोगको जोखिम बढि हुन्छ । विशेषगरी ब्राण्डका नाम उल्लेख नगरिएका जारका पानी अशुद्ध रहेको नास्टको रिपोर्टमा उल्लेख छ ।
कोलिफर्म तथा इकोलाए नामक जिवाणु हाम्रो शरीरमा प्रवेश गरेमा झाडापखाला, वान्ता, हैजा तथा जण्डिस जस्ता रोग लाग्ने गर्दछन् । नास्टले गरेको अध्ययनमा जार मात्र नभएर ट्याङकर तथा धाराको पानी पनि पिउन योग्य रहेका छैनन् । नास्टले यी पानीहरु नउमाली तथा राम्रोसँग शुद्धिकरण नगरी नपिउन आग्रह गरेको छ । शुक्रराज ट्रपिकल तथा सरुवा रोग महाशाखाका अनुसन्धान कोडिनेटर डा. शेर बहादुर पुनका अनुसार पछिल्लो समय जारको पानी पिउने परिवारका सबै सदस्य नै झाडापखालाका कारण अस्पताल आउने क्रम बढ्दै गएको छ ।
उनले आफ्नो फेसबुक पेजमा नास्टले हालै गरेको अध्ययन र त्यसपछि आएको रिपोर्टप्रति पूर्ण समर्थन जनाउँदै आफूले यस विषयमा धेरै पहिलादेखि नै आवाज उठाउँदै आएको कुरा नास्टले प्रमाणित गरिदिएको बताएका छन् । हेरौं उनको फेसबुक स्टाटस जस्ताको तस्तै :